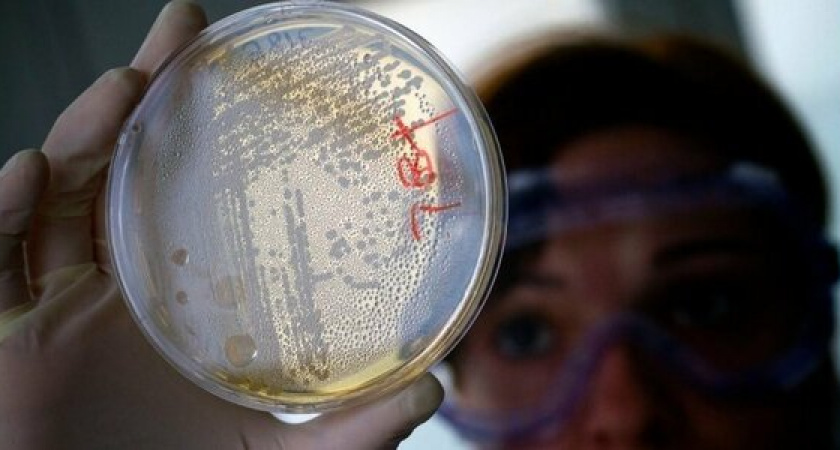
«Рекомендуем пить кипяченую воду»: в Роспотребнадзоре Новороссийска прокомментировали ситуацию с эпидемией кишечной инфекции в станице Раевской

«Рекомендуем пить кипяченую воду»: в Роспотребнадзоре Новороссийска прокомментировали ситуацию с эпидемией кишечной инфекции в станице Раевской
- 12 октября 2018
- Оксана Силакова
Вчера, 11 октября 2018 года, в социальных сетях Новороссийска стала распространяться информация, что в станице Раевской свирепствует эпидемия кишечной инфекции.
По версии жителей, в инфекционную больницу были госпитализированы около полусотни человек, а источником инфекции стала водопроводная вода.
Однако вчера никаких официальных заявление по данному поводу не последовало.
Сегодня НАШЕЙ удалось связаться с руководителем отдела Роспотребнадзора в г. Новороссийске Диной Кардаиловой.
По ее словам, в ночь с 10 на 11 октября было зафиксировано 11 случаев экстренной госпитализации взрослых и детей с острой кишечной инфекцией неизвестной этиологии.
Нас смутило то, что все больные были из одного населенного пункта — станицы Раевской. Утром мы выехали в станицу, провели обследование водопроводных сетей, провели обследование школы. Расследование проводили специалисты Управления Роспотребнадзора РФ по Краснодарскому краю. Все пробы, которые мы отобрали из объектов внешней среды (готовая продукция, смывы на патогенную и непатогенную микрофлору, воду) находятся в работе. Пока дожидаемся результатов, есть предположение, что все-таки где-то произошло загрязнение водопровода, поэтому с профилактической целью МУП «Водоканал» совместно с муниципалитетом проводят дезинфекцию и чистку всех водопроводных сетей и накопительных емкостей. Но однозначно это утверждать нельзя. Надо дождаться результатов анализов. Расследование продолжается. Идет поиск источника инфекции. Разрабатывается план профилактических и противоэпидемических мероприятий по локализации очага заболевания. Проводится полный комплекс противоэпидемических мероприятий, чтобы не позволить распространиться данному заболеванию. Бригады объезжают людей, которые контактировали с больными. Некоторых людей провизорно госпитализируют, чтобы провести обследование, так как у них могут не проявляться симптомы, но они могут быть носителями инфекции. Также мы пока рекомендуем пить кипяченую воду.
Дина Кардаилова
В пресс-службе МУП «Водоканал» сообщили, что на данный момент отрабатываются три версии произошедшего. Официальное заявление будет сделано по результатам анализов.
